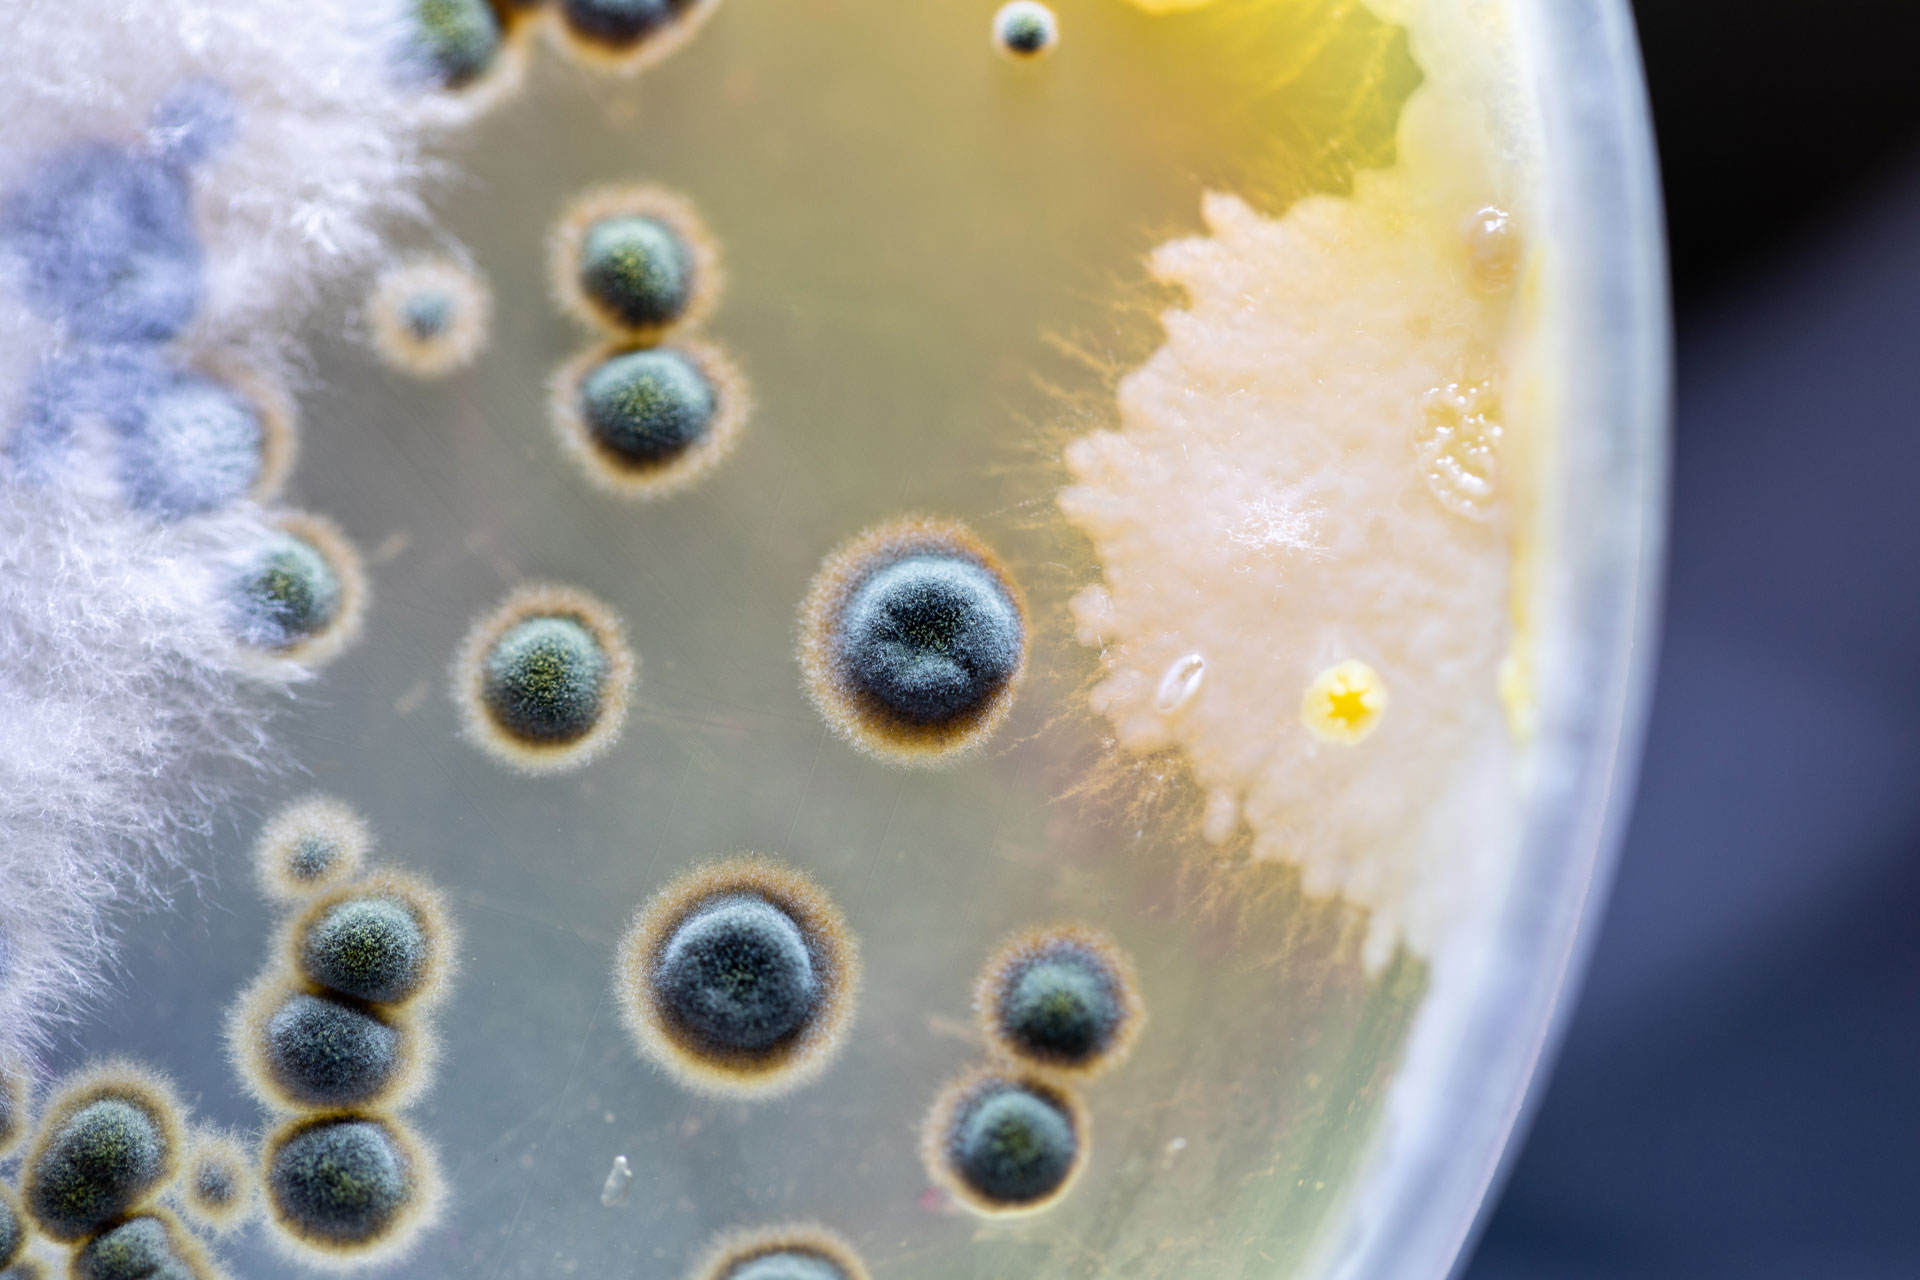
Colonies of bacteria and funghi in Petriglass“: © Adobe Stock

CHALLENGE MICROBIOLGICAL CONTAMINATION IN PULP & PAPER INDUSTRY
Slime-free.
Germ-free.
Flawless.
We ensure control over microbiological growth
If you are confronted with slimy deposits, clogged pipes and filters, undesirable odors, spoiled raw and auxiliary materials and defects in the end product, uncontrolled growth of bacteria, fungi and algae may be the cause.
Our many years of experience in the field of microbiological control make us a competent problem solver.
With efficient solutions, we maintain and increase your productivity and ensure the quality of your end products:
Depending on the specific conditions under which undesirable microbiology grows and thrives as determined during the system survey, our application experts, supported by test results from our in-house analytics laboratory, select the ideal treatment strategy for your task.
Causes of microbiological contamination
As most substances and additives used in the paper industry and related industries are solutions or emulsions in a highly diluted aqueous environment, this provides an excellent breeding ground for the proliferation of microorganisms such as bacteria, yeasts and fungi.
The entire paper machine cycle provides ideal conditions for the growth of microorganisms:
- pH and temperature
- Content of dissolved oxygen
- Broad nutritient supply for microorganisms:
- Chemicals and auxiliary materials
- Fibers and fines
- Trace elements
- Hydrodynamic properties of the circuit
STANDARDS
We rely on interdisciplinary expertise

This means that our laboratory and application technology experts work on an interdisciplinary basis to develop the ideal treatment strategy and that the efficiency of the treatment is ensured by laboratory analysis accompanying the application.
All necessary analyses are carried out in our in-house laboratory by our experts.
Our analytics professionals identify the causes of microbiological contamination and provide our application specialists with a valuable basis for developing an efficient treatment plan.


ProduCTS AND SYSTEMS
Efficient solution to control microbiological activity:


